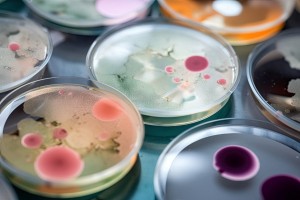

-
Impacts and mechanisms of biochar on soil microorganisms
Biochar is an eco-friendly material with strong adsorption properties, widely used for improving soil and water quality. It enhances soil conditions and supports microbial communities by increasing microbial abundance, improving nutrient content, and providing a suitable habitat. Biochar’s effects depend on various factors, such as the raw material used, application dose, pH, and pyrolysis temperature. It helps retain nutrients, reduces nutrient loss, and improves water retention. Biochar also promotes soil aggregation by supporting fungal and actinomycete growth, which aids in nitrogen cycling and other essential soil processes.
Read more about "Impacts and mechanisms of biochar on soil microorganisms"
-
Release of poly- and perfluoroalkyl substances from AFFF-impacted soils: Effects of water saturation in vadose zone soils
This study investigates the release of PFASs from aqueous film-forming foam (AFFF)-impacted soils under constant and variably saturated conditions. PFASs, used in fire suppression foam, contaminate soils and pose long-term groundwater risks. Previous research shows that air-water interfaces in unsaturated soils complicate PFAS release. The study used field-collected vadose zone soils in column experiments with artificial rainwater, flushing under both constant and variably saturated conditions. Effluents were analyzed for a range of PFASs to evaluate how unsaturated conditions affect PFAS flux to groundwater. The findings aim to improve understanding of PFAS release dynamics in the unsaturated zone.
Read more about "Release of poly- and perfluoroalkyl substances from AFFF-impacted soils: Effects of water saturation in vadose zone soils"
-
Unlocking the potential of soil microbial communities for bioremediation of emerging organic contaminants: omics-based approaches
The article examines the potential of soil microbial communities and advanced omics technologies to tackle environmental contamination caused by emerging organic contaminants (EOCs). These contaminants, which include pharmaceuticals, pesticides, microplastics, and industrial chemicals, present significant risks to ecosystems and human health.
Read more about "Unlocking the potential of soil microbial communities for bioremediation of emerging organic contaminants: omics-based approaches"
-
Emission of Microplastics to Water, Soil, and Air. What can we do about it?
Microplastics enter the environment through plastic-containing products. The Dutch authorities aim to identify the main sources of these emissions in the Netherlands as to develop measures to reduce microplastic emissions.
Read more about "Emission of Microplastics to Water, Soil, and Air. What can we do about it?"
-
Avoiding the Next Silent Spring: Our Chemical Past, Present, and Future
The authors explore the environmental and health impact of persistent chemicals, specifically per- and polyfluoroalkyl substances (PFAS), and compare it to Rachel Carson's 1962 book Silent Spring, which exposed the dangers of DDT and leading to stricter regulations and environmental awareness.
Read more about "Avoiding the Next Silent Spring: Our Chemical Past, Present, and Future"
-
The Global Threat from the Irreversible Accumulation of Trifluoroacetic Acid (TFA)
This study emphasizes the alarming environmental and health implications of trifluoroacetic acid (TFA), a type of perfluoroalkyl acid (PFAA), which is by far the most abundant PFAS compound in the environment. TFA, which was initially associated with the degradation of fluorinated refrigerants introduced as alternatives for ozone-depleting CFCs, has become increasingly alarming due to its widespread presence in drinking water and human blood.
Read more about "The Global Threat from the Irreversible Accumulation of Trifluoroacetic Acid (TFA)"
-
PFAS levels and determinants of variability in exposure in European teenagers – Results from the HBM4EU aligned studies (2014–2021)
The HBM4EU (Human Biomonitoring for Europe) project focuses on PFAS (perfluoroalkyl and polyfluoroalky substances) exposure levels among European teenagers and investigates the factors influencing these levels. PFAS are synthetic chemicals found in consumer products, and their persistence in the environment makes them bioaccumulate in humans and wildlife.
Read more about "PFAS levels and determinants of variability in exposure in European teenagers – Results from the HBM4EU aligned studies (2014–2021)"
-
Mycoremediation as a Potentially Promising Technology: Current Status and Prospects—A Review
The study provides a comprehensive analysis of the potential and current advancements in mycoremediation, the bioremediation technology using fungi to degrade environmental pollutants.
Read more about "Mycoremediation as a Potentially Promising Technology: Current Status and Prospects—A Review"
-
Microplastics and Potentially Toxic Elements: Potential Human Exposure Pathways through Agricultural Lands and Policy-Based Countermeasures
Microplastics and potentially toxic elements (PTEs) in agricultural systems are subject to a growing concern with regards to food safety. Microplastics, which have more and more become recognized as soil pollutants, can adsorb PTEs, such as heavy metals, increasing their mobility and potential absorption by plants.
Read more about "Microplastics and Potentially Toxic Elements: Potential Human Exposure Pathways through Agricultural Lands and Policy-Based Countermeasures"
-
Developing a groundwater watch list for substances of emerging concern: a European perspective
There is concern of the growing presence of unregulated anthropogenic substances, such as pharmaceuticals and PFAS, in European groundwater. The EU Groundwater Watch List (GWWL) was established, a voluntary initiative designed to identify and monitor substances that pose risks to groundwater quality.
Read more about "Developing a groundwater watch list for substances of emerging concern: a European perspective"
